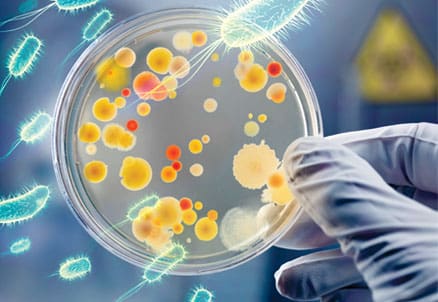

Salud y Familia
Extraen un nuevo antibiótico de una bacteria que habita en el suelo de una selva mexicana
La fazolicina, producida por una bacteria simbiótica del género Rhizobium, defiende las raíces de las leguminosas.
Un grupo de científicos rusos y estadounidenses ha descubierto un nuevo antibiótico creado por una bacteria que habita en los nódulos de las raíces del frijol silvestre, natural de la reserva de la biosfera de Los Tuxtlas, en el estado mexicano de Veracruz. Los resultados del hallazgo fueron expuestos en un artículo publicado este martes en la revista Nature Communications.
Se detalla que la sustancia, bautizada ‘fazolicina’, se produce por una bacteria no identificada del género Rhizobium, conocido por su capacidad de fijar el nitrógeno y por sus relaciones simbióticas con las leguminosas. La especie, que está por ser establecida, combina esas cualidades con la protección del organismo huésped de bacterias maliciosas, haciéndolo más robusto y saludable.

Según los investigadores, la fazolicina “es interesante por su modo idiosincrásico de interacción con el ribosoma” de las bacterias, ya que puede penetrar dentro de sus membranas e impedirles de producir proteínas.
Asimismo, indican que el hallazgo puede tener importantes aplicaciones “como un agente potencial para el biocontrol en la agricultura“.
“Esperamos mostrar que la bacteria se puede usar como probiótico de plantas, porque la fazolicina evitará que otras bacterias potencialmente dañinas crezcan en el sistema de raíces de plantas de importancia agrícola”, comentó Konstantin Severinov, uno de los autores del estudio, en un comunicado de la Universidad Rutgers.
Asimismo, resaltó que la búsqueda de nuevos antibióticos es “un gran problema tanto en la medicina como en la agricultura” y promueve “una continua búsqueda” de fármacos de este tipo.
Si te ha gustado, ¡compártelo con tus amigos!
-

 Regionales2 días ago
Regionales2 días agoIsmael arranca obras de infraestructura en Juárez
-

 Zitácuaro2 días ago
Zitácuaro2 días agoREUBICAN MONUMENTO AL PERIODISTA MANUEL BUENDÍA EN ZITÁCUARO
-

 Seguridad2 días ago
Seguridad2 días agoUna motociclista resulta lesionada tras una colisión en Zitácuaro
-

 Seguridad3 días ago
Seguridad3 días agoReportan motociclista lesionado tras accidente en la carretera Morelia-Zitácuaro
-

 México2 días ago
México2 días agoTormenta tropical Boris genera alerta por lluvias torrenciales en el Pacífico mexicano
-

 Congreso2 días ago
Congreso2 días agoTeresita Herrera Maldonado plantea iniciativa para garantizar la seguridad de menores en juicios familiares
-

 Michoacán2 días ago
Michoacán2 días agoProtección Civil de Michoacán mantiene monitoreo en la región oriente ante la tormenta tropical Boris
-

 Medio Ambiente2 días ago
Medio Ambiente2 días agoSuspenden clases presenciales en ocho municipios de Michoacán por fenómeno meteorológico “Boris”


